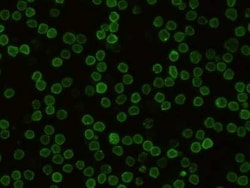
CD48/SLAMF2 Rabbit anti-Mouse, Clone: 341, Novus Biologicals:Antibodies:Primary

missing translation for 'onlineSavingsMsg'
Learn More
Learn More
CD48/SLAMF2 Rabbit anti-Mouse, Clone: 341, Novus Biologicals™
Rabbit Monoclonal Antibody
£307.00 - £448.00
Specifications
| Antigen | CD48/SLAMF2 |
|---|---|
| Clone | 341 |
| Dilution | Flow Cytometry 1:25-1:100, Immunocytochemistry/Immunofluorescence 1:20-1:100, Sandwich ELISA Detection 1:1000-1:10000 |
| Applications | Flow Cytometry, Immunofluorescence, ELISA |
| Classification | Monoclonal |
| Product Code | Brand | Quantity | Price | Quantity & Availability | |||||
|---|---|---|---|---|---|---|---|---|---|
| Product Code | Brand | Quantity | Price | Quantity & Availability | |||||
|
18287177
|
Novus Biologicals
NBP2-90577-50UL |
50 μg |
£307.00
50µL |
Please sign in to purchase this item. Need a web account? Register with us today! | |||||
|
18274717
|
Novus Biologicals
NBP2-90577-100UL |
100 μg |
£448.00
100µL |
Please sign in to purchase this item. Need a web account? Register with us today! | |||||
Description
CD48/SLAMF2 Monoclonal specifically detects CD48/SLAMF2 in Mouse samples. It is validated for Flow Cytometry, Immunocytochemistry/Immunofluorescence, Sandwich ELISA Detection.Specifications
| CD48/SLAMF2 | |
| Flow Cytometry 1:25-1:100, Immunocytochemistry/Immunofluorescence 1:20-1:100, Sandwich ELISA Detection 1:1000-1:10000 | |
| Monoclonal | |
| Purified | |
| RUO | |
| Mouse | |
| BCM1 surface antigen, BCM1Leukocyte antigen MEM-102, BLAST, BLAST1TCT.1, B-lymphocyte activation marker BLAST-1, CD48 antigen, CD48 antigen (B-cell membrane protein), CD48 molecule, hCD48, mCD48, MEM-102, SLAMF2 | |
| Recombinant Mouse CD48/SLAMF2 protein | |
| Primary | |
| Store at 4°C short term. Aliquot and store at -20°C long term. Avoid freeze-thaw cycles. |
| 341 | |
| Flow Cytometry, Immunofluorescence, ELISA | |
| Unconjugated | |
| Rabbit | |
| Cell Biology, Cellular Markers, Immunology, Stem Cell Markers | |
| 0.2 um filtered solution in PBS | |
| 962 | |
| IgG | |
| Protein A purified |
Spot an opportunity for improvement?Share a Content Correction
Product Content Correction
Your input is important to us. Please complete this form to provide feedback related to the content on this product.
Product Title